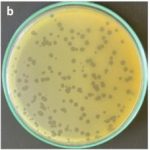

Modern Medicine and Holistic Health: A New Era in Healthcare
The healthcare landscape is undergoing a dramatic transformation, and we’re seeing modern medicine and alternative therapies working together more than ever before. In my view, this blend of science and holistic approaches brings fresh hope and challenges in equal measure. Patients today have more options to choose from, and understanding both the benefits and potential pitfalls can be overwhelming. This editorial aims to provide a neutral perspective on how different healthcare methods can complement one another, while offering insights that are super important for anyone looking to take control of their health.
Modern medicine has long been the cornerstone of effective treatment, diagnosis, and prevention. Yet over the years, alternative therapies have garnered interest for their ability to address those tricky parts and hidden complexities that standard practices sometimes miss. As we figure a path through this evolving terrain, we’ll explore topics ranging from integrative care to the fine points of nutrition, and from personalized health journeys to disease prevention strategies that balance both medical and holistic paradigms.
Integrative Healthcare Approaches for Chronic Disease Management
One of the most intriguing developments in recent years is the rise of integrative healthcare. This approach blends modern treatments with alternative therapies such as acupuncture, herbal remedies, and mindfulness practices. The persuasion behind integrative care is that by addressing not only the symptoms but also the root causes, patients can enjoy improved overall well-being.
Many chronic conditions, including diabetes, arthritis, and even heart disease, benefit from a balanced treatment plan. While conventional methods offer vital treatments like medication and surgery, alternative practices may help ease the nerve-racking side effects and uncomfortable symptoms. For example, acupuncture is often used to soothe pain, and dietary changes can work hand in hand with prescribed drugs to control blood sugar levels or reduce inflammation.
Holistic Approaches to Pain Relief and Inflammation Reduction
When tackling chronic pain, many patients face a confusing mix of treatments. Standard painkillers, physical therapy, and even surgical interventions may be complemented with holistic methods such as massage therapy, yoga, and meditation. These alternative strategies aren’t meant to replace medical examinations, but they can play a critical role in managing pain, reducing stress, and ultimately improving quality of life.
Herbal supplements like turmeric and ginger have shown promise in reducing inflammation, a common underlying problem in many diseases. In many cases, blending these remedies with conventional care helps to manage the tricky parts of chronic ailments, offering patients additional ways to steer through their health challenges without undue reliance on prescription medications.
Nutrition and Diet: Balancing Science with Holistic Wisdom
Nutrition remains a cornerstone of health, and both modern science and alternative medicine recognize the need for a balanced diet. However, when it comes to nutrition advice, there’s no one-size-fits-all solution. While mainstream nutritionists emphasize calorie counting and macronutrients, many holistic practitioners stress the importance of whole foods, seasonal eating, and balance in the diet.
Healthy Eating Habits for Lifelong Wellness
Developing a balanced diet can sometimes feel intimidating with so much conflicting information. Whether it’s the latest superfood trend or age-old herbal remedies, consumers are bombarded with choices. It’s essential, though, to tune into your own body’s signals. Eating nutrient-dense foods such as leafy greens, lean protein, and whole grains can help provide steady energy and support the immune system.
Dietary adjustments might also include mindful strategies such as portion control and scheduled meal times. These practices can lead to improved digestion and enhanced metabolism, which, in turn, support a healthier lifestyle overall. Additionally, experimenting with recipes that incorporate both modern dietary guidelines and ancient food wisdom can result in meals that are both delicious and beneficial.
Long-Term Benefits of Nutrient-Rich Diets
A nutrient-rich diet not only prevents disease conditions but also bolsters mental health. A growing body of research suggests that diets high in omega-3 fatty acids, vitamins, and antioxidants can lead to reduced inflammation and enhanced cognitive function. Foods like salmon, walnuts, and berries are celebrated for their anti-inflammatory properties and are a testament to how super important nutrition can be in our day-to-day lives.
When you practice balanced eating, the rewards extend to better mood management, sharper concentration, and even improved sleep patterns. In this light, nutritional health might be considered not just as a complementary approach, but as co-equal to modern therapies in the pursuit of overall wellness.
Fitness and Physical Activity: The Intersection of Exercise and Medicine
Physical activity embodies a key element in preventing and managing many health conditions. The idea of combining tailored exercise routines with medical treatments is gaining ground as more studies confirm that physical fitness can play a key role in recovery and disease prevention.
Exercise as a Pillar of Preventative Health
From cardio routines to strength training, exercise not only helps maintain a healthy weight, but it also supports cardiovascular health and improves mental wellbeing. Whether you’re a seasoned athlete or a beginner, regular physical activity can profoundly impact your daily energy levels and overall health profile. Many experts argue that exercise can reduce the nerve-racking risk of conditions such as obesity, hypertension, and type 2 diabetes.
Moreover, the rising awareness of the benefits of exercise has given birth to various programs that integrate fitness with other treatments. For instance, rehabilitation programs often include physical therapy exercises designed to enhance mobility and reduce the little twists that accompany chronic pain. In this environment, exercise is both a preventive measure and a recovery tool.
Innovative Approaches to Exercise in Modern Healthcare
Today’s fitness programs are not just about hitting the gym; they also encompass modern technologies, personalized training sessions, and even digital health monitoring. Wearable devices and fitness trackers give real-time insights into heart rate, caloric burn, and sleep quality, enabling individuals to take a closer look at their fitness journey. Such tools empower patients to make more informed decisions about their exercise routines, ensuring that the chosen activities match their unique health needs.
In addition to conventional methods, many people are now turning to group exercises like yoga and Pilates, which offer both physical and mental benefits. Group classes foster a sense of community and accountability, which can be the extra push needed on days when motivation falters. In essence, designing a personal workout plan that cuts across different disciplines might be the super important counterbalance to a sedentary lifestyle.
Modern Medicine and Alternative Therapies: Bridging the Gap
It’s clear that modern medicine and alternative therapies each have their own strengths and limitations. While modern medicine excels in acute care, surgery, and the rapid treatment of life-threatening conditions, alternative methods shine when it comes to addressing the subtle parts of stress, chronic pain, and overall life balance. The real progress in healthcare, in my opinion, lies in finding a middle ground where these two paradigms converge.
Evaluating the Benefits and Limitations of Both Systems
The benefits of contemporary medicine are many: quick diagnosis, advanced imaging, and potent medications known to save lives. However, there are cases where the side effects of aggressive pharmaceutical treatments or the nerve-racking aftermath of surgical procedures call for a gentler touch—one that alternative therapies might offer. Many patients report reduced anxiety and improved holistic well-being after integrating practices such as meditation or herbal supplements into their regimen.
On the other hand, the world of alternative medicine is sometimes critiqued for its lack of rigorous clinical testing. Nonetheless, a growing number of peer-reviewed studies are shedding light on the efficacy of various complementary treatments. In this evolving dialogue, it’s crucial for both systems to work hand in hand, providing the best possible outcomes for patients.
Risk Management in Integrative Treatments
While the integrated approach to healthcare holds great promise, it’s essential to address the full set of risks involved. Combining treatments from different paradigms can sometimes lead to unwanted interactions or side effects. For example, certain herbal supplements might interfere with prescribed medications, leading to complications if not carefully managed. This is why a coordinated effort between all providers—whether in a hospital or a wellness center—is super important.
Transparency, communication, and regular monitoring are the cornerstones of any integrative treatment plan. Patients should feel encouraged to discuss all aspects of their healthcare with every provider involved. With honest conversations and the sharing of subtle details, individuals can ensure that the combined treatments are safe and effective.
Personalizing Health Journeys: The Intersection of Genetics, Lifestyle, and Environmental Factors
One size does not fit all in the world of healthcare. Today, there’s increasing recognition that personalized medicine, which tailors treatments based on genetics, lifestyle, and environmental inputs, can offer promising outcomes. This approach digs into the fine points of individual health, making it possible to craft a treatment plan that is as unique as the patient themselves.
Genetic Insights: The Role of Personalized Medicine
The mapping of the human genome has opened doors to understanding the small distinctions that set each person apart. Genetic testing is now being used not only to diagnose diseases but also to predict how patients might respond to certain treatments. This can help doctors and wellness practitioners figure a path that minimizes trial and error, ensuring that each patient gets the care that best suits their individual makeup.
In practice, this means that treatments—from the drugs prescribed to the diet recommendations offered—can be finely tuned to the individual’s genetic profile. Personalized medicine is particularly promising in fields such as oncology, where an understanding of genetic mutations can drastically alter treatment strategies and improve survival rates.
Lifestyle Factors and Their Impact on Long-Term Health
While genetics play a crucial role, lifestyle factors like diet, exercise, and stress management are equally significant. An individual’s habits can either counterbalance or exacerbate genetic predispositions to certain diseases. For instance, smoking or excessive alcohol consumption might turn a minor genetic risk into a significant health problem. Conversely, a healthy lifestyle can help mitigate these risks even for those genetically predisposed to chronic conditions.
It’s important to recognize that lifestyle modifications can be one of the most effective strategies in preventing complex health issues. This approach is not about imposing strict regimes, but rather about discovering a balanced way of living that harmonizes physical, mental, and even emotional well-being.
Preventative Healthcare: Strategies for a Healthier Future
Preventative healthcare is one of the most exciting areas where modern medicine and alternative approaches converge. By catching diseases early or even preventing them entirely, the quality of life for many can be significantly improved. The real challenge here is to work through the tangled issues of accessibility, education, and individualized care.
Early Detection and Routine Screenings
Both modern and alternative medicine stress the importance of early detection. Routine screenings, blood tests, and imaging studies are all methods through which doctors can uncover issues before they escalate into nerve-racking emergencies. In the realm of alternative therapies, regular wellness checks—be it through traditional Chinese diagnostic techniques or Ayurvedic pulse readings—are also highly valued.
The secret to successful early detection is a proactive approach. For many patients, incorporating regular check-ups into their lifestyle is not just super important; it’s a key step in identifying and mitigating future health risks. In practice, a combination of technology and intuition from alternative healing arts can help people stay one step ahead.
Community Health Programs and Preventative Lifestyle Changes
The responsibility of preventative care doesn’t lie solely with individual patients; community programs also play a significant role. Governments, non-profit organizations, and private entities are all working together to provide education, resources, and support for healthier lifestyles. These programs often emphasize balanced diets, regular exercise, and stress management—areas where modern science and holistic practices overlap beautifully.
Workshops, fitness classes, and nutritional counseling sessions are a few examples of community efforts to promote health. In many cases, these initiatives also include guidance on alternative therapies like meditation and acupuncture, reinforcing the idea that prevention is best achieved through a well-rounded approach.
Bridging the Gap Between Doctor and Patient: Communication and Trust
One of the most critical factors in any healthcare approach is the relationship between doctors and patients. Effective communication can ease the intimidating experience of medical diagnoses and treatments, as well as the confusing bits of alternative therapies. It’s essential for patients to feel heard and understood, no matter which path they choose to manage their health.
Effective Communication in a Multi-Disciplinary Setting
The healthcare field is full of little details—from understanding lab results to discussing the pros and cons of combined treatments—that can seem overwhelming at first. Clearly explaining procedures, expected outcomes, and potential side effects helps patients manage their expectations and reduces anxiety. Whether during a conventional medical consultation or a holistic wellness session, clarity and transparency are super important.
- Ask Questions: Never hesitate to ask your healthcare provider to explain fine points in simple terms.
- Make Notes: Jotting down what is discussed during appointments can help you review and understand later.
- Seek Clarification: If something doesn’t make sense, request further explanation.
These practical steps foster a sense of trust and collaboration between patients and healthcare providers, ensuring that both parties work together in finding your best path forward.
Patient Education and Empowerment
Encouraging patients to play an active role in their health care is one of the most effective strategies to improve outcomes. Access to reliable information about both modern and alternative treatments enables individuals to make informed decisions. This is where initiatives such as patient education workshops, online resources, and community support groups come into play. By digging into the subtle details of their conditions and available treatments, patients can gain confidence in their ability to manage their health.
Healthcare is evolving, and patients now have unprecedented access to information that was once locked away in academic journals or hospital offices. The digital age has empowered many to take charge of their health, bridging the old divide between patient and provider and allowing for a more democratic, well-informed approach to wellness.
Looking Ahead: The Future of Healthcare Integration
The integration of modern medicine with alternative therapies is an ongoing journey, constantly reshaped by emerging research, technological advances, and changing patient needs. As we look ahead, several exciting trends and innovations promise to further revolutionize the healthcare space.
Technological Advances in Health Monitoring and Diagnostics
Wearable technology and telemedicine are two areas where modern medicine is making great strides. These innovations allow for continuous monitoring of key health indicators, making it easier to catch the small distinctions that might otherwise go unnoticed. Devices that track heart rate, sleep patterns, and physical activity are becoming more sophisticated, giving both patients and doctors a closer look at the body’s responses to treatment and lifestyle changes.
At the same time, telemedicine is making healthcare more accessible, especially for those in remote or underserved areas. Virtual consultations can help bridge the gap between specialist advice and patient needs, ensuring that everyone can get the care they require without enduring nerve-racking delays. Combined with home-based diagnostic tools and apps that keep track of your health data, the future of integrative healthcare is looking both promising and inclusive.
Research and Collaboration: Fusing Traditional Wisdom with Modern Science
One of the most exciting prospects on the horizon is increased collaboration between researchers and practitioners across the spectrum of healthcare. As more studies validate alternative therapies, the medical community becomes increasingly open to combining the best of both worlds. Collaborative research initiatives are working to understand the subtle parts of alternative practices, from the fine shades of acupuncture’s effects to subtle details in herbal medicine formulations.
This joint effort is paving the way for novel treatment protocols that address chronic diseases, mental health challenges, and even complex conditions like autoimmune disorders. The mutual exchange of ideas not only enriches modern medical practices but also lends credibility to alternative approaches. In essence, the future of healthcare lies in working together and embracing diverse perspectives.
Concluding Thoughts: A Balanced Path Forward
After reflecting on the current state of healthcare, I am convinced that the most promising models are those that harmonize the strengths of modern medicine with the wisdom of alternative therapies. While each system has its own set of challenges—be it the nerve-racking side effects of aggressive drugs or the tricky parts of insufficiently tested herbal remedies—the combined approach offers a broader range of options for patients.
In balancing these approaches, one must recognize that healthy living is a multifaceted journey. It involves not only rigorous scientific testing and technological innovations but also the nurturing of body, mind, and spirit through holistic practices. The path to wellness is like navigating a labyrinth of tangled issues and subtle details; the key is to remain open, informed, and proactive about your health.
There is no doubt that the future will bring more opportunities for innovation, and with them, the chance for better integration between disciplines. Healthcare professionals, researchers, and patients alike will continue to learn from each other, slowly constructing a system that is both flexible and resilient. Ultimately, the goal is to create an environment where every individual can find their own balance between modern treatments and holistic care—allowing them to achieve and maintain long-lasting health.
Key Takeaways from an Integrated Healthcare Perspective
- Integration Is the Future: Combining modern medicine with alternative therapies provides a more comprehensive approach to health.
- Personalization Is Critical: Tailoring treatments based on genetic, lifestyle, and environmental factors is emerging as a must-have strategy.
- Preventative Care Works: Regular screenings, proper nutrition, and physical activity are fundamental in preventing major health issues.
- Effective Communication: Clear dialogue between patients and professionals is essential in managing combined treatment plans.
- Embrace Technology: Innovations such as wearable devices and telemedicine are revolutionizing how we monitor and manage health.
By recognizing the strengths and weaknesses of each method, we can build a health care system that is both robust and adaptable. Patients are more informed than ever, and their active participation in managing their wellness has helped drive this shift toward more integrated care.
This balanced approach to health care does not require abandoning conventional methods, nor does it mean indiscriminately accepting alternative ones. Rather, it is about working through the tangled issues that arise from a single-method approach and embracing a system that’s built on collaboration, flexibility, and a commitment to individualized care. As we step into this new era, let us remain vigilant and open-minded, always ready to find your way through the maze of modern healthcare with an informed, integrative mindset.
Final Reflections on the Journey of Healthcare Evolution
In closing, the journey toward a fully integrated healthcare system is an ongoing process—one that involves continuous learning, adaptation, and cooperation among all stakeholders. Whether you prefer modern medicine or lean towards alternative therapies, the most important takeaway is that being proactive about your health is essential. Educate yourself, ask questions, and don’t be afraid to explore a variety of treatment options. By doing so, you can piece together the best possible care plan that fits your unique needs and lifestyle.
Healthcare is not static; it evolves as new research emerges and as society’s needs shift. The coming years will likely see even deeper integration between different medical paradigms, spurred on by technological advances and innovative research. As we face the future, the responsibility lies with each of us to stay informed and engaged. Remember, your health is a journey—a lifelong process of making choices that shape a better, healthier tomorrow.
Let us continue to champion a future where the collaboration between modern and alternative therapies isn’t just a trend, but a permanent pillar of comprehensive care. By embracing the full spectrum of available treatments—with careful attention to the fine points and little details of each—we can all contribute to building a healthcare system that is as diverse and unique as the individuals it serves.
Originally Post From https://www.mensjournal.com/news/nfl-player-bryan-braman-battling-very-rare-cancer
Read more about this topic at
Plagiarism Quiz Answers – Current students
Help! Turnitin flagged my paper at 97% AI??? : r/GradSchool